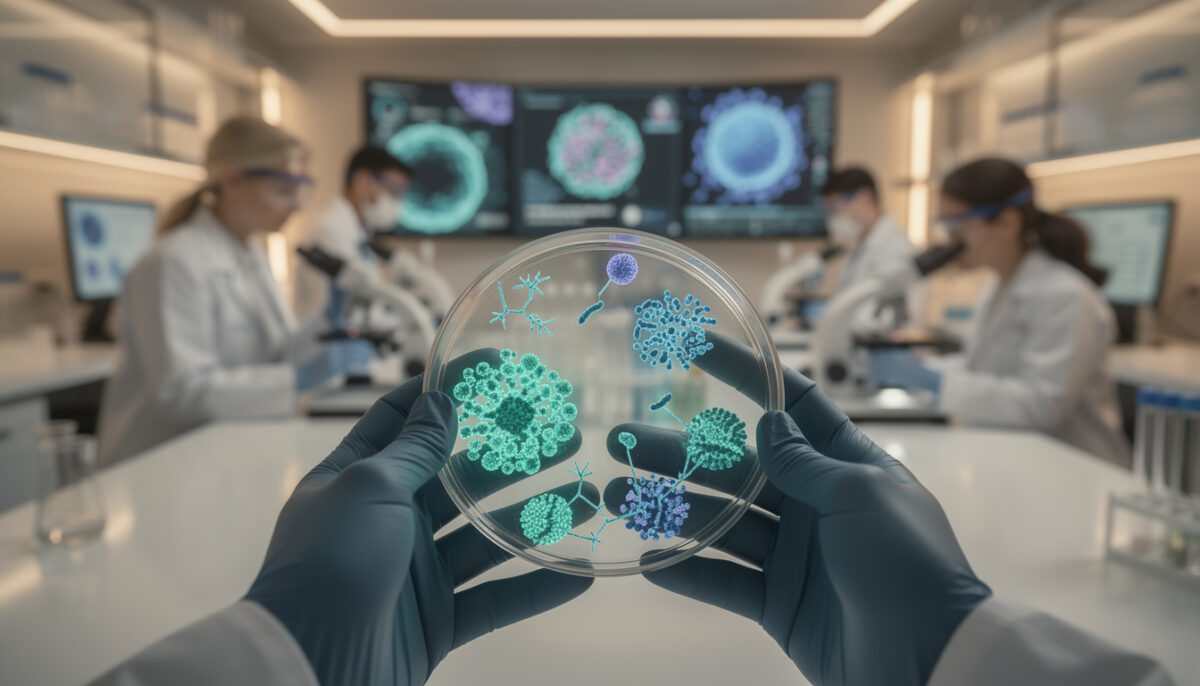
probiotic cancer therapy

Show summary Hide summary
Your next cancer treatment might not be a pill or an infusion, but a living micro “factory” that sneaks into tumors and attacks from inside. Scientists are now turning familiar probiotic cancer therapy bacteria into precision tumor-targeting cancer fighters capable of hunting down tumors while sparing healthy tissue.
How engineered probiotic bacteria hunt tumors
Cancer still affects millions every year, and conventional therapies often struggle to distinguish between malignant and healthy cells. Scientists noticed something surprising: certain bacteria naturally migrate and grow inside tumors, attracted by low oxygen and disorganized blood vessels. Instead of seeing this as a threat, researchers decided to transform them into allies.
A team led by Tianyu Jiang used the probiotic strain Escherichia coli Nissle 1917 (EcN), already known from gut health products. Through modern biotechnology and genetic engineering, they reprogrammed EcN so it behaves like a microscopic guided missile, homing in on tumors and activating only once safely inside the cancerous tissue. Read more about how bacteria use unexpected tactics to move without propellers to infiltrate environments like tumors.
A 10-second home strength test could predict your life expectancy—but most people flunk it. Here’s why it matters.
Scientists claim a 4-week diet made older adults biologically younger—here’s what’s real, what’s hype, and why it matters more than you think
The Romidepsin “on-board pharmacy” inside EcN
To turn this probiotic into a genuine therapeutic tool, the team loaded it with Romidepsin (FK228), an FDA‑approved anticancer drug. Instead of injecting Romidepsin into the bloodstream, they encoded the bacterial genome so EcN itself could produce the molecule directly inside the tumor, drastically increasing local concentration and limiting exposure for the rest of the body.
In mouse models of breast cancer, these engineered microbes colonized tumors after injection. Under specific conditions, they started synthesizing Romidepsin in situ, acting as self-driving drug depots. This living delivery system lays the groundwork for future therapeutics where medicine is continuously produced only where needed most.
Dual-action strategy: colonization plus cancer killing
The strength of this approach lies in its double effect. First, the probiotic EcN preferentially accumulates within tumor tissue, a phenomenon already observed in other studies such as those on engineered probiotic bacteria attacking tumors in mouse models. Second, once established, the bacteria release Romidepsin and damage nearby cancer cells.
The authors describe this as a dual‑action cancer therapy: tumor colonization reshapes the local microenvironment, while the drug attacks malignant cells at short range. This combined pressure makes it harder for the tumor to adapt or hide, especially when paired with the immune system’s response to bacterial presence. Dive deeper into how a revolutionary iron-based nanomaterial targets cancer cells while preserving healthy tissue using advanced delivery techniques.
From targeted delivery to immune education
Other groups have already shown that tumor‑seeking microbes can teach the immune system to recognize cancer more effectively. For instance, Columbia University researchers demonstrated that bacterial “vaccines” can train immune cells to track primary tumors and metastases, a concept detailed in their work on hacking bacteria to attack cancer.
In Jiang’s model, Romidepsin adds another layer by altering gene expression in cancer cells. This can increase their visibility to immune cells, combining bacterial targeting with drug‑induced vulnerability. The result: precision tumor-targeting fighters that operate both as delivery vehicles and immune system amplifiers. Also, explore more about how scientists unveiled a bacterial kill switch for safer and smarter bacterial therapies.
Why the gut microbiome is becoming a cancer ally
This work fits into a much broader movement: using the human microbiome as a medical toolkit. Over the last decade, research on gut microbes has reshaped how medicine views metabolism, immunity, and even mood, as highlighted by reports on the power of our microbiome. Cancer therapy is now catching up with this revolution.
Probiotic strategies tap into the body’s own ecology. Instead of flooding every cell with chemotherapy, Scientists aim to place customized bacteria at battlefronts such as tumors, inflamed tissues, or even the oral cavity, an emerging field explored in work on the oral microbiome. The same design logic now guides tumor-specific bacterial platforms.
Key advantages of bacteria-assisted oncology
Compared with classic approaches, bacteria-based cancer therapeutics offer several strategic benefits that matter for future patients and clinicians:
- High precision: Tumor-homing microbes minimize contact with healthy organs, reducing systemic toxicity.
- On-site production: Drugs are synthesized directly at the tumor, allowing lower overall doses.
- Programmability: Genetic circuits can be adjusted to respond only to specific tumor signals.
- Combination potential: Bacteria can be paired with immunotherapy, radiotherapy, or targeted agents.
- Repeat dosing: Living systems can be re-administered or temporarily colonize until treatment ends.
These strengths explain why tumor‑targeting bacteria are now seen as a serious pillar of next‑generation oncology, not a futuristic curiosity.
Limits, risks and next steps before human trials
The current EcN‑Romidepsin system remains at the preclinical stage. Experiments in mice demonstrated tumor colonization and drug release under different conditions, yet translating this into safe human use will require several layers of validation. Researchers must show that engineered microbes can be switched off or eliminated once therapy is complete.
Possible side effects also need careful monitoring: unwanted colonization in other organs, excessive immune reactions, or genetic drift in the bacteria over time. Regulatory agencies will look closely at containment strategies, kill switches, and methods to track microbes after administration, especially for repeatedly dosed patients.
Design questions for future cancer fighters
Jiang’s work raises key design questions that every future platform will need to answer. Which probiotic backbone is safest: EcN, another commensal strain, or a synthetic chassis? How many tumor-targeting genes and safety circuits can be layered without destabilizing the bacteria?
Future teams may combine several payloads—cytotoxic molecules, immune stimulators, and signaling inhibitors—inside a single microbial vehicle. Articles like engineering the gut to fight cancer already discuss this shift toward modular, programmable bacteria able to adapt to each patient’s tumor profile.
From lab to clinic: what this could mean for you
Imagine a patient like Alex, 47, whose breast tumor resisted standard lines of therapy. A few years from now, instead of escalating toxicity, Alex’s oncologist could propose a course of engineered probiotic cancer therapy bacteria. After infusion, these microbes would patrol the bloodstream, settle only in malignant tissue, and quietly start manufacturing Romidepsin-like agents.
Regular imaging and blood tests would monitor both tumor response and bacterial presence. Once the tumor shrinks below a predetermined threshold, antibiotics or built‑in genetic switches would clear the microbes. For patients juggling work, family, and long hospital days, the promise of fewer side effects and shorter infusions could change daily life as much as survival statistics.
How do probiotic bacteria know where a tumor is located?
Engineered probiotic bacteria exploit physical and chemical differences between tumors and healthy tissues. Solid tumors often have low oxygen, disrupted blood vessels, and specific nutrients that attract microbes. Scientists program strains like Escherichia coli Nissle 1917 to survive and grow mainly in these abnormal zones, turning them into living sensors that accumulate where cancer cells are concentrated.
Is using bacteria to treat cancer safe for the rest of the body?
Safety is the central focus of this new field. Researchers add genetic ‘kill switches’ so the bacteria die if they leave the tumor environment or if a particular drug is given. They also monitor where the microbes travel in animal models before any human trial. Although early results are promising, full safety evaluation in people will be necessary before clinical use.
Why did scientists choose Romidepsin for this study?
Romidepsin (FK228) is an FDA-approved anticancer agent with well-documented activity and known dosing limits. By loading it into tumor-targeting bacteria, scientists can concentrate the drug directly inside cancer tissue and potentially use lower total amounts. This makes it an ideal first candidate to test whether bacterial biosynthesis and local delivery can match or improve current systemic administration.
Could these engineered bacteria replace chemotherapy?
Scientists Warn: This Everyday Sweetener May Be Quietly Rewiring Your Metabolism—Here’s What They Aren’t Telling You Yet
This 800-year-old Chinese exercise is lowering blood pressure in 2024—why experts say it’s nothing like yoga or mainstream stress fixes
Most teams see bacteria-based therapeutics as partners rather than complete replacements. In many scenarios, they will likely be combined with chemotherapy, radiotherapy, or immunotherapy to improve precision and reduce side effects. Over time, if clinical trials show strong results, some patients could switch from broad systemic regimens to more targeted bacterial approaches tailored to their tumor type.
When might patients realistically access bacteria-based cancer therapies?
Several platforms are currently moving from mouse models toward early-phase human studies. Timelines depend on safety data, regulatory reviews, and manufacturing capacity. If upcoming trials confirm the benefits seen in animals, first-generation precision tumor-targeting bacterial therapies could reach specialized cancer centers within the next decade, initially for patients with limited alternatives.


